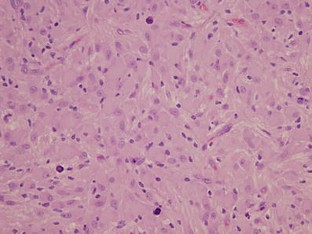

Abstract
Objects
Congenital Subependymal giant cell astrocytoma (SEGA), diagnosed in fetal and neonatal period, is extremely rare. Previous studies have reported poor surgical outcomes of this small group of patients. We encountered a patient diagnosed as congenital SEGA and report the surgical outcome along with interesting immuno-phenotypes of giant tumor cells.
Case
Ventriculomegaly and a hypoechoic mass near the foramen of Monro were detected in a fetus on prenatal ultrasonography in the 35th week of gestation. Surgery was scheduled 2 months later to reduce the risk of operative complications. At postnatal 2 months, gross total resection of the tumor was achieved without complications. The patient had been followed up for 1 year without tumor recurrence. In double immunofluorescence, the prototype cells of SEGA expressed a variety of neural stem cell (nestin and Sox2) and radial glial cell markers (vimentin and brain lipid-binding protein), in addition to glutamate/aspartate transporter and glial fibrillary acidic protein.
Conclusions
Congenital SEGA can be successfully treated with judicious use of observation period and careful evaluation of general conditions. Pathological findings support the concept that SEGA may originate from aberrant radial glial cells in the developing brain.

Similar content being viewed by others
References
Baron Y, Barkovich AJ (1999) MR imaging of tuberous sclerosis in neonates and young infants. AJNR Am J Neuroradiol 20:907–916
Crino PB, Nathanson KL, Henske EP (2006) The tuberous sclerosis complex. N Engl J Med 355:1345–1356
Ess KC, Kamp CA, Tu BP, Gutmann DH (2005) Developmental origin of subependymal giant cell astrocytoma in tuberous sclerosis complex. Neurology 64:1446–1449
Gotz M, Huttner WB (2005) The cell biology of neurogenesis. Nat Rev Mol Cell Biol 6:777–788
Howard B, Chen Y, Zecevic N (2006) Cortical progenitor cells in the developing human telencephalon. Glia 53:57–66
Kim SK, Wang KC, Cho BK, Jung HW, Lee YJ, Chung YS, Lee JY, Park SH, Kim YM, Choe G, Chi JG (2001) Biological behavior and tumorigenesis of subependymal giant cell astrocytomas. J Neurooncol 52:217–225
Levine D, Barnes P, Korf B, Edelman R (2000) Tuberous sclerosis in the fetus: second-trimester diagnosis of subependymal tubers with ultrafast MR imaging. AJR Am J Roentgenol 175:1067–1069
Medhkour A, Traul D, Husain M (2002) Neonatal subependymal giant cell astrocytoma. Pediatr Neurosurg 36:271–274
Meikle L, Talos DM, Onda H, Pollizzi K, Rotenberg A, Sahin M, Jensen FE, Kwiatkowski DJ (2007) A mouse model of tuberous sclerosis: neuronal loss of Tsc1 causes dysplastic and ectopic neurons, reduced myelination, seizure activity, and limited survival. J Neurosci 27:5546–5558
Mirkin LD, Ey EH, Chaparro M (1999) Congenital subependymal giant-cell astrocytoma: case report with prenatal ultrasonogram. Pediatr Radiol 29:776–780
Oikawa S, Sakamoto K, Kobayashi N (1994) A neonatal huge subependymal giant cell astrocytoma: case report. Neurosurgery 35:748–750
Painter MJ, Pang D, Ahdab-Barmada M, Bergman I (1984) Connatal brain tumors in patients with tuberous sclerosis. Neurosurgery 14:570–573
Phi JH, Park SH, Paek SH, Kim SK, Lee YJ, Park CK, Cho BK, Lee DH, Wang KC (2007) Expression of Sox2 in mature and immature teratomas of central nervous system. Mod Pathol 20:742–748
Raju GP, Urion DK, Sahin M (2007) Neonatal subependymal giant cell astrocytoma: new case and review of literature. Pediatr Neurol 36:128–131
Ramenghi LA, Verrotti A, Domizio S, Di Rocco C, Morgese G, Sabatino G (1996) Neonatal diagnosis of tuberous sclerosis. Child’s Nerv Syst 12:121–123
Souweidane MM (2008) Brain tumors in the first two years of life. Principles and practice of pediatric neurosurgery. Georg Thieme, Stuttgart, pp 489–510
Sparagana SP, Roach ES (2000) Tuberous sclerosis complex. Curr Opin Neurol 13:115–119
Taylor MD, Poppleton H, Fuller C, Su X, Liu Y, Jensen P, Magdaleno S, Dalton J, Calabrese C, Board J, Macdonald T, Rutka J, Guha A, Gajjar A, Curran T, Gilbertson RJ (2005) Radial glia cells are candidate stem cells of ependymoma. Cancer Cell 8:323–335
Tien RD, Hesselink JR, Duberg A (1990) Rare subependymal giant-cell astrocytoma in a neonate with tuberous sclerosis. AJNR Am J Neuroradiol 11:1251–1252
Zecevic N (2004) Specific characteristic of radial glia in the human fetal telencephalon. Glia 48:27–35
Acknowledgment
This study was supported by a grant (no. 7-2005-1216; to Kim S. K.) from the Korean Ministry of Health and Welfare.
Author information
Authors and Affiliations
Corresponding author
Rights and permissions
About this article
Cite this article
Phi, J.H., Park, SH., Chae, J.H. et al. Congenital subependymal giant cell astrocytoma: clinical considerations and expression of radial glial cell markers in giant cells. Childs Nerv Syst 24, 1499–1503 (2008). https://doi.org/10.1007/s00381-008-0681-x
Received:
Published:
Issue Date:
DOI: https://doi.org/10.1007/s00381-008-0681-x




